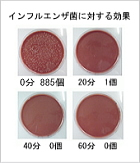

|
殺菌・消臭 ナノテクビーム |
 |
 |
■金沢大学と共同研究開発
ナノテクビームとは金沢大学との共同開発により、今迄と違った(オゾン・高電圧・触媒施工・薬剤・香料等を一切使用せず) 超微弱電流を利用した、まったく新しい世界初の画期的な消臭・殺菌装置です。
メンテナンスもフィルター交換のみです
。
★ 平成16年特許取得済み★
マイナスイオン200万個発生と、マイナスイオンが強力なナノテクビームイオンと変わり、効果も絶大になります。お客様の為に安心・安全な状態でリラックスして愉しんでいただけると確信しております。 |
|
|
殺菌・消臭 ナノテクビーム 導入による臭気レベルデータ |
 |
|
ナノテクビームの細菌に対する試験データ |
■ ナノテクビームはインフルエンザ菌などへの優れた効果を大学で試験されており、 感染予防などにお勧めできます。
■ 杏林大学医学部感染症学 神谷教授グループが、研究報告書 「ナノテクビームとマイナスイオンの病原性細胞に対する効果の研究」を発表, さらに2回目も対象菌を11種増やし、発表されました。 |
|
第1回試験:
平成17年9月22日、杏林大学医学部感染症学 神谷教授グループは、当社の空気消臭器 「ナノテクビームとマイナスイオンの病原性細胞に対する効果の研究」報告書を発表しました。
被検菌種は、10種類(インフルエンザ菌、ネズミチフス菌・緑膿菌・B群赤痢菌・肺炎球菌・肺炎桿菌・ 肺炎マイコプラズマ菌、腸管出血性大腸菌O-157、メチシリン耐性黄色ブドウ球菌MRSA、メチシリン感受性黄色ブドウ球菌MSSA)です。
この研究報告書により、「ナノテクビーム」とマイナスイオンの顕著な結果が出ました。 |
 |
第2回試験
さらに平成19年に、細菌、および真菌合計11種類(腸球菌、セレウス菌、腸炎菌、ネズミチフス菌、霊菌、エロモナス・ソブリア、セパシア菌、ナグビブリオ、腸炎ビブリオ、ピロリ菌ならびにカンジダ・アルビカンス)を試験し、ナノテクビームは 病原細菌に対して有用であるとの評価を得ました。 |
|
|